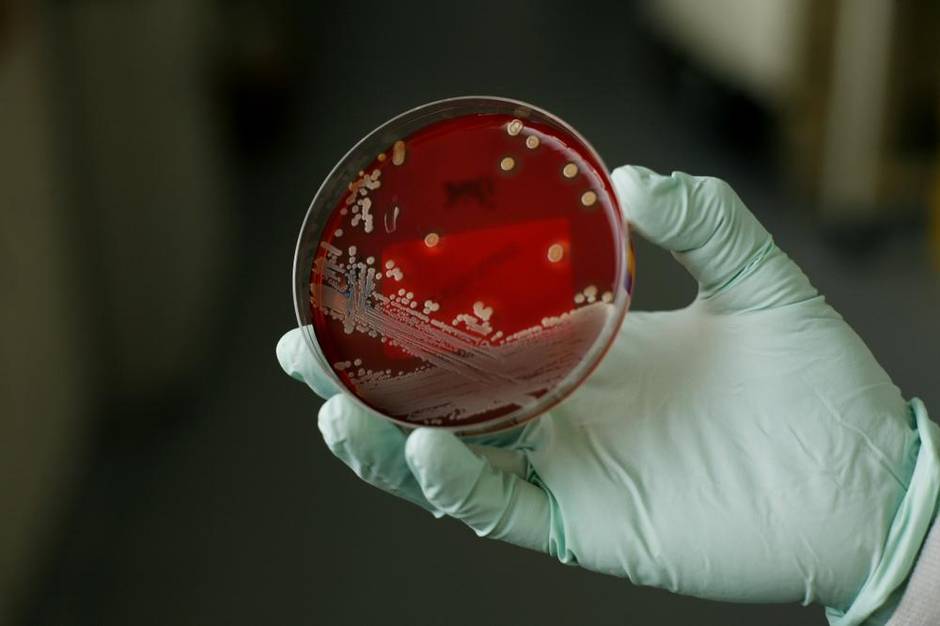

It’s a nightmarish thought: You go into the hospital for a relatively simple procedure, come in contact with a superbug and fall deathly ill.
That scenario played out on a large scale in Los Angeles last month when it came to light that insufficient cleaning of a frequently used scope exposed dozens of people to drug-resistant microbes and led to the death of at least two patients. It seemed we had taken a step closer toward the fast-approaching, post-antibiotic era when superbugs turn routine surgeries into life-threatening procedures, and even the most common infections are incurable.
On Tuesday, Health Canada issued its first report on nationwide antibiotic use and drug resistance rates, reporting that superbugs have already cost Canadians $1-billion in medical care. The report noted a 14-fold increase in the use of last-line antibiotics to treat difficult infections since 2002, and that one in 23 hospitalized Canadians stands to become infected with the superbug known as MRSA.
Already, more than 18,000 patients here acquire multi-drug-resistant strains of bacteria each year. And while no good data on related death rates are available, Health Canada reported in November that deaths directly related to Clostridium difficile have increased five-fold in the past decade. In the E.U. and the U.S., hospital-acquired infections kill a total of 50,000 people each year.
The World Health Organization has called it a global emergency.
So what’s being done to fight MRSA (methicillin-resistant Staphylococcus aureus), CRE (carbapenem-resistant Enterobacteriaceae), VRE (vancomycin-resistant Enterococcus) and other antibiotic-resistant superbugs that – fuelled by overuse and misuse in agriculture and human health care – threaten to force modern medicine back to an archaic time?
Around the world, governments are crafting legislation to accurately track and control how antibiotics are prescribed and taken, pouring hundreds of millions of dollars into the development of new drugs, and even altering regulations around clinical trials to ensure potential antibiotics get tested faster. But will it be enough?
Preparing superbug strategies
Facing the real possibility of entering a post-antibiotic era this century, British Prime Minister David Cameron urged former Goldman Sachs chief Jim O’Neill last year to provide a global economist’s view of the problem: Concluding that drug-resistant superbugs could kill some 10 million people annually and cost up to $100-trillion by 2050, O’Neill called for a global fund to develop new antibiotics.
The European Union had already backed its 2011 Action Plan against Antimicrobial Resistance with combined investment of €650-million ($890-million) that includes both conservation and stewardship of existing antimicrobials (including bacteria-killing antibiotics and drugs that target a wider range of microbes such as fungi) and investment into new drugs.
In January, U.S. President Barack Obama committed an unprecedented $1.2-billion to fight antibiotic resistance: More than half of the money would be invested in new drug development, while giving the Centers for Disease Control and Prevention $280-million to halt the spread of drug-resistant superbugs.
On March 27, in a report that involved the departments of health, agriculture and defence, Obama elaborated: Along with investment in drug development, he would use the threat of financial penalties to encourage the reporting of antibiotic overprescribing by doctors who take part in Medicare or Medicaid.
For its part, Health Canada has just released a Federal Action Plan on Antimicrobial Resistance and Use, promising the creation of an antimicrobial resistance surveillance system, launching a $20-million, five-year project to help understand and mitigate antimicrobial resistance under the federal Genomics Research and Development Initiative, and committing to increase research investment through the Canadian Institutes of Health Research-funded Canada-Britain partnership and other CIHR-funded projects.
On March 31, Health Canada and the Public Health Agency of Canada also released a report from the newly created Canadian Antimicrobial Resistance Surveillance System (CARSS), following a round-table discussion that included leaders from the food industry, veterinary and human medicine, pharmacy and an expert in drug-resistant microbes.
The report concluded that when it comes to superbug infection rates, there has been no significant improvement despite existing surveillance programs, and the surveillance picture in Canada is far from complete. The authors did say CARSS will provide a better understanding of the issues by “directing the expansion of surveillance activities to areas of greatest need.”
That said, experts worry the Canadian plan lacks the timelines and budget to have a meaningful impact.
Dr. Andrew Morris, who runs the antimicrobial stewardship program at Mount Sinai Hospital and the University Health Network in Toronto, and who was at the Health Minister’s round-table discussion, says “our government, in dealing with the issue of antibiotic resistance and antibiotics, has been very slow to the table” compared with the E.U. and the U.S.
Doctors on the front lines increasingly feel they’re fighting a losing battle.
“I have a patient here who is on colistin – it is not even an antibiotic, it is a detergent,” Morris says. “We stopped using it for decades but it is one of the few drugs that we can still use.”
It’s a crude weapon against an ever more powerful enemy. And even colistin, one of those last-line drugs that are increasingly being used in Canada, is losing its potency.
Last fall, the European Centre for Disease Prevention and Control reported for the first time on cases of resistance to this drug in the fight against Klebsiella pneumoniae.

The importance of stewardship
Tracking superbug infection rates (surveillance) is one piece of the puzzle. Tracking the use of antibiotics (stewardship) is another.
In Canada, CARSS purchases data from a company called IMS Health Canada Inc. on prescriptions dispensed by retail pharmacies (70 per cent of all antibiotics used in Canada), antimicrobials purchased by Canadian hospitals (30 per cent) and diagnoses for which physicians have recommended antibiotics in the community. CARSS reports that the use of antibiotics has declined in communities and hospitals since 2001. Still, while some data are collected, in most cases officials can’t tell if the antibiotic was prescribed correctly (doctors have been known to prescribe antibiotics for sore throats caused by viruses, not bacteria), or if it was taken correctly by patients.
And though it’s widely accepted that monitoring the appropriate use of antibiotics is critical in halting the spread of resistance, only a handful of Canadian hospitals have antimicrobial stewardship programs. These programs use sophisticated software (and specially trained personnel) to track antibiotic use in intensive-care units to ensure individual patients are prescribed appropriate antibiotics at the right time, take them for the exact duration needed or change prescriptions if required. In unmonitored hospital ICUs, correct use of antibiotics occurs in only half of cases. Under stewardship, that rate jumps to 80 per cent, according to Dr. Charles Frenette, medical director of infection prevention at McGill University Health Centre in Montreal.
Following a successful stewardship program at Mount Sinai and UHN, Ontario helped establish programs in 14 ICUs around the province in 2011. Encouragingly, the use of antibiotics in these ICUs has fallen by 23 per cent since then, resulting in a 16-per-cent cut in antibiotic costs. Twelve more hospitals joined this past fall; now all teaching hospitals in the province have systems in place to monitor antibiotic use.
At the national level, Accreditation Canada, a not-for-profit organization that sets and checks safety standards in health care, responded to requests from physicians and made it mandatory in 2013 for all accredited hospitals to monitor antibiotic use in ICUs. But according to its first report, only half of the 79 surveyed hospitals had implemented such programs within the first year.
Right now, most hospitals “can’t even pass the accreditation benchmark, and we are not asking very high levels,” Morris notes. “This is a bare minimum – it is pathetic.” Any attempt to construct a national picture of antibiotic use and misuse will be undermined by poor data collection in many provinces.
“We don’t have experts, we don’t have money for the experts, we don’t have systems and we don’t have money for the systems. So what they are asking is to improve antimicrobial prescribing by getting people who are non-experts to rely on poor data to improve it,” Morris said. “And that’s why we are moving very slowly. It is a dollar-sensitive investment issue: If there was a willingness to invest in the training and education of experts and invest in data systems, then we would move ahead very quickly – which means in five to seven years.”

The need for new weapons
Even if hospitals and family physicians get a handle on infection rates and the overuse and misuse of antibiotics, new drugs are desperately needed to tackle the superbugs that have already outwitted modern medicine.
Today, few big pharmaceutical companies are working to bring new antibiotics to market: It takes about $1-billion to develop a drug, and only one in five compounds that are tested on humans are approved for use.
The chances of recouping investment in a new antibiotic are slim because, unlike some other drugs that are taken daily for years, generating huge profits, antibiotics are typically used for only a week or two at a time. And there is the inescapable occurrence of resistance – the bacteria will always fight back. What’s more, almost 40 per cent of newly approved antibiotics end up being withdrawn because they are deemed too toxic, further slashing the prospects of major profits for their makers, explains economist Ramanan Laxminarayan, director at the Center for Disease and Dynamics, Economics and Policy in Washington.
To counter the built-in disincentives to antibiotic development, the U.S. passed the 2012 Generating Antibiotic Incentives Now (GAIN) Act to give promising new antibiotics priority review and make them more profitable by doubling their period of market exclusivity to 10 years. Five new antibiotics have been approved this way in the U.S. alone in the past 12 months, equalling the number in the previous decade.
Regulatory changes that would make it easier and faster to recruit patients and move to the clinical trial stage have been cited as a critical in the fight against antibiotic-resistant bugs.
To address this, the Europeans and Americans are working together to establish new regulations. The U.S. Congress is considering a bill, known as the Promise for Antibiotics and Therapeutics for Health (PATH) Act, which should streamline clinical trials for antibiotics that can treat superbugs. Health Canada told The Globe that, at this time, there’s no need to change regulations “given that the science and guidelines to conduct trials evolve continually, and the current framework provides sufficient flexibility to accommodate changes in clinical trial design.”
Dr. Gerard Wright, director of the Michael G. DeGroote Institute for Infectious Disease Research at McMaster University in Hamilton, is optimistic that, with dedicated investment, the superbug battle can be won.
“I’ve been working in this field for 25 years, and I’ve never seen so much interest in antimicrobial resistance. I am confident that we can solve this problem.”
Jovana Drinjakovic is a neuroscientist and a Fellow in Global Journalism at the Munk School at the University of Toronto.